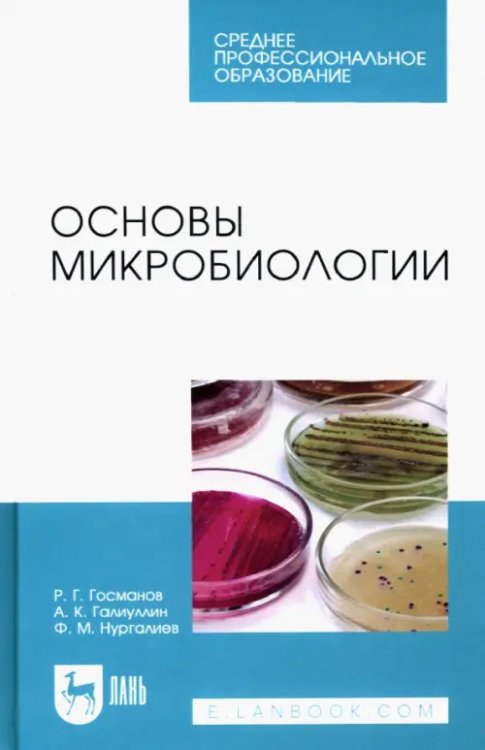
Основы микробиологии. Учебник для СПО

Аннотация: Основы микробиологии. Учебник для СПО
Учебник состоит из трех разделов. В первом разделе изложены сведения по морфологии, физиологии, генетике и экологии микроорганизмов, описано значение микроорганизмов в природе, жизни человека и животных, а также превращения микроорганизмами соединений азота и углерода, формы взаимоотношений в мире микробов, антибиотики, влияние факторов внешней среды на микроорганизмы.
Второй раздел посвящен основам учения об инфекции и иммунитете, понятиям патогенности и вирулентности.
Третий раздел - лабораторные занятия - посвящен микробиологическим, культуральным, биохимическим методам исследования, правилам отбора, доставки и хранения биоматериала и серологическим методам диагностики инфекционных болезней животных.
Предназначен для студентов СПО, обучающихся по специальности "Ветеринария".
3-е издание стереотипное.
| Автор/составитель | Госманов Рауис Госманович, Галиуллин Альберт Камилович, Нургалиев Фарит Муллагалиевич |
| Серия | Учебники для ВУЗов. Специальная литература |
| Год выпуска | 2023 |
| ISBN | 978-5-507-44150-1, 978-5-507-46276-6, 978-5-507-47390-8, 978-5-8114-3936-2, 978-5-8114-7112-6 |
| Производитель | Лань |
| Издательство | Лань |
| Количество томов | 1 |
| Количество страниц | 144 |
| Переплет | Твёрдый переплёт |
| Размеры | 207x135x12 мм |
| Цвет | Голубой |
| Тип бумаги | офсетная (60-220 г/м2) |
| Вес | 212 |
| Язык | русский |